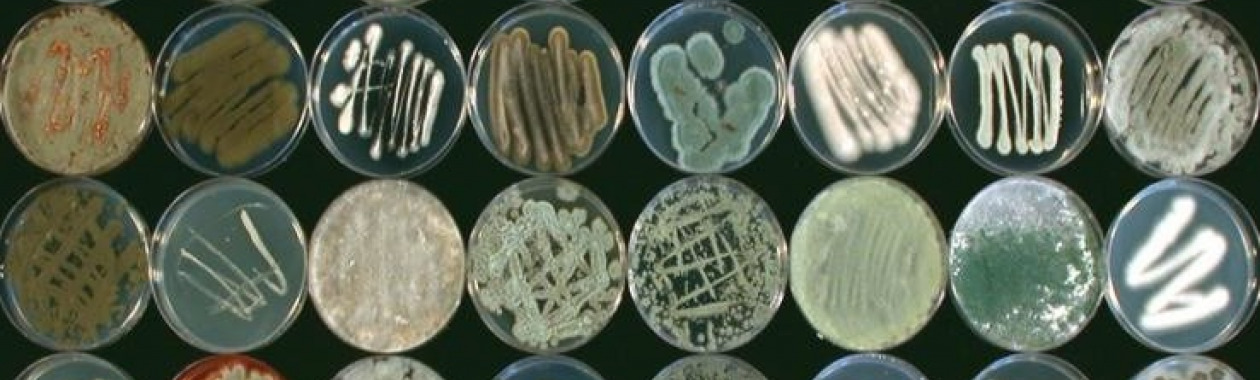
environmental fungal collection

About the Department
The Department of Plantpathology and Microbiology aims at discovering, understanding, and applying novel principles and approaches to improve agriculture along with improving the environment. This challenge is addressed through theory, experiments and field studies, linking the computer to the bench to the field, applied to our common passion for microorganisms. This passion permeates our teaching, from basic courses to advanced classes.
The department's researchers study bacteria and fungi, how they grow and multiply, their interactions with plants as pathogenic or as beneficial agents; how they organize in communities and the molecular tools they use to perform important ecological functions such as degrading organic waste, recycle wastewater or affect the life of pest insects.
Research is performed with state of art methodologies and technologies in mathematical modeling, molecular biology, bioinformatics and systems biology, and microscopy, conjugated with classical and high throughput microbiological approaches. The department hosts Israeli as well as many international graduate students and post-doctoral fellows.